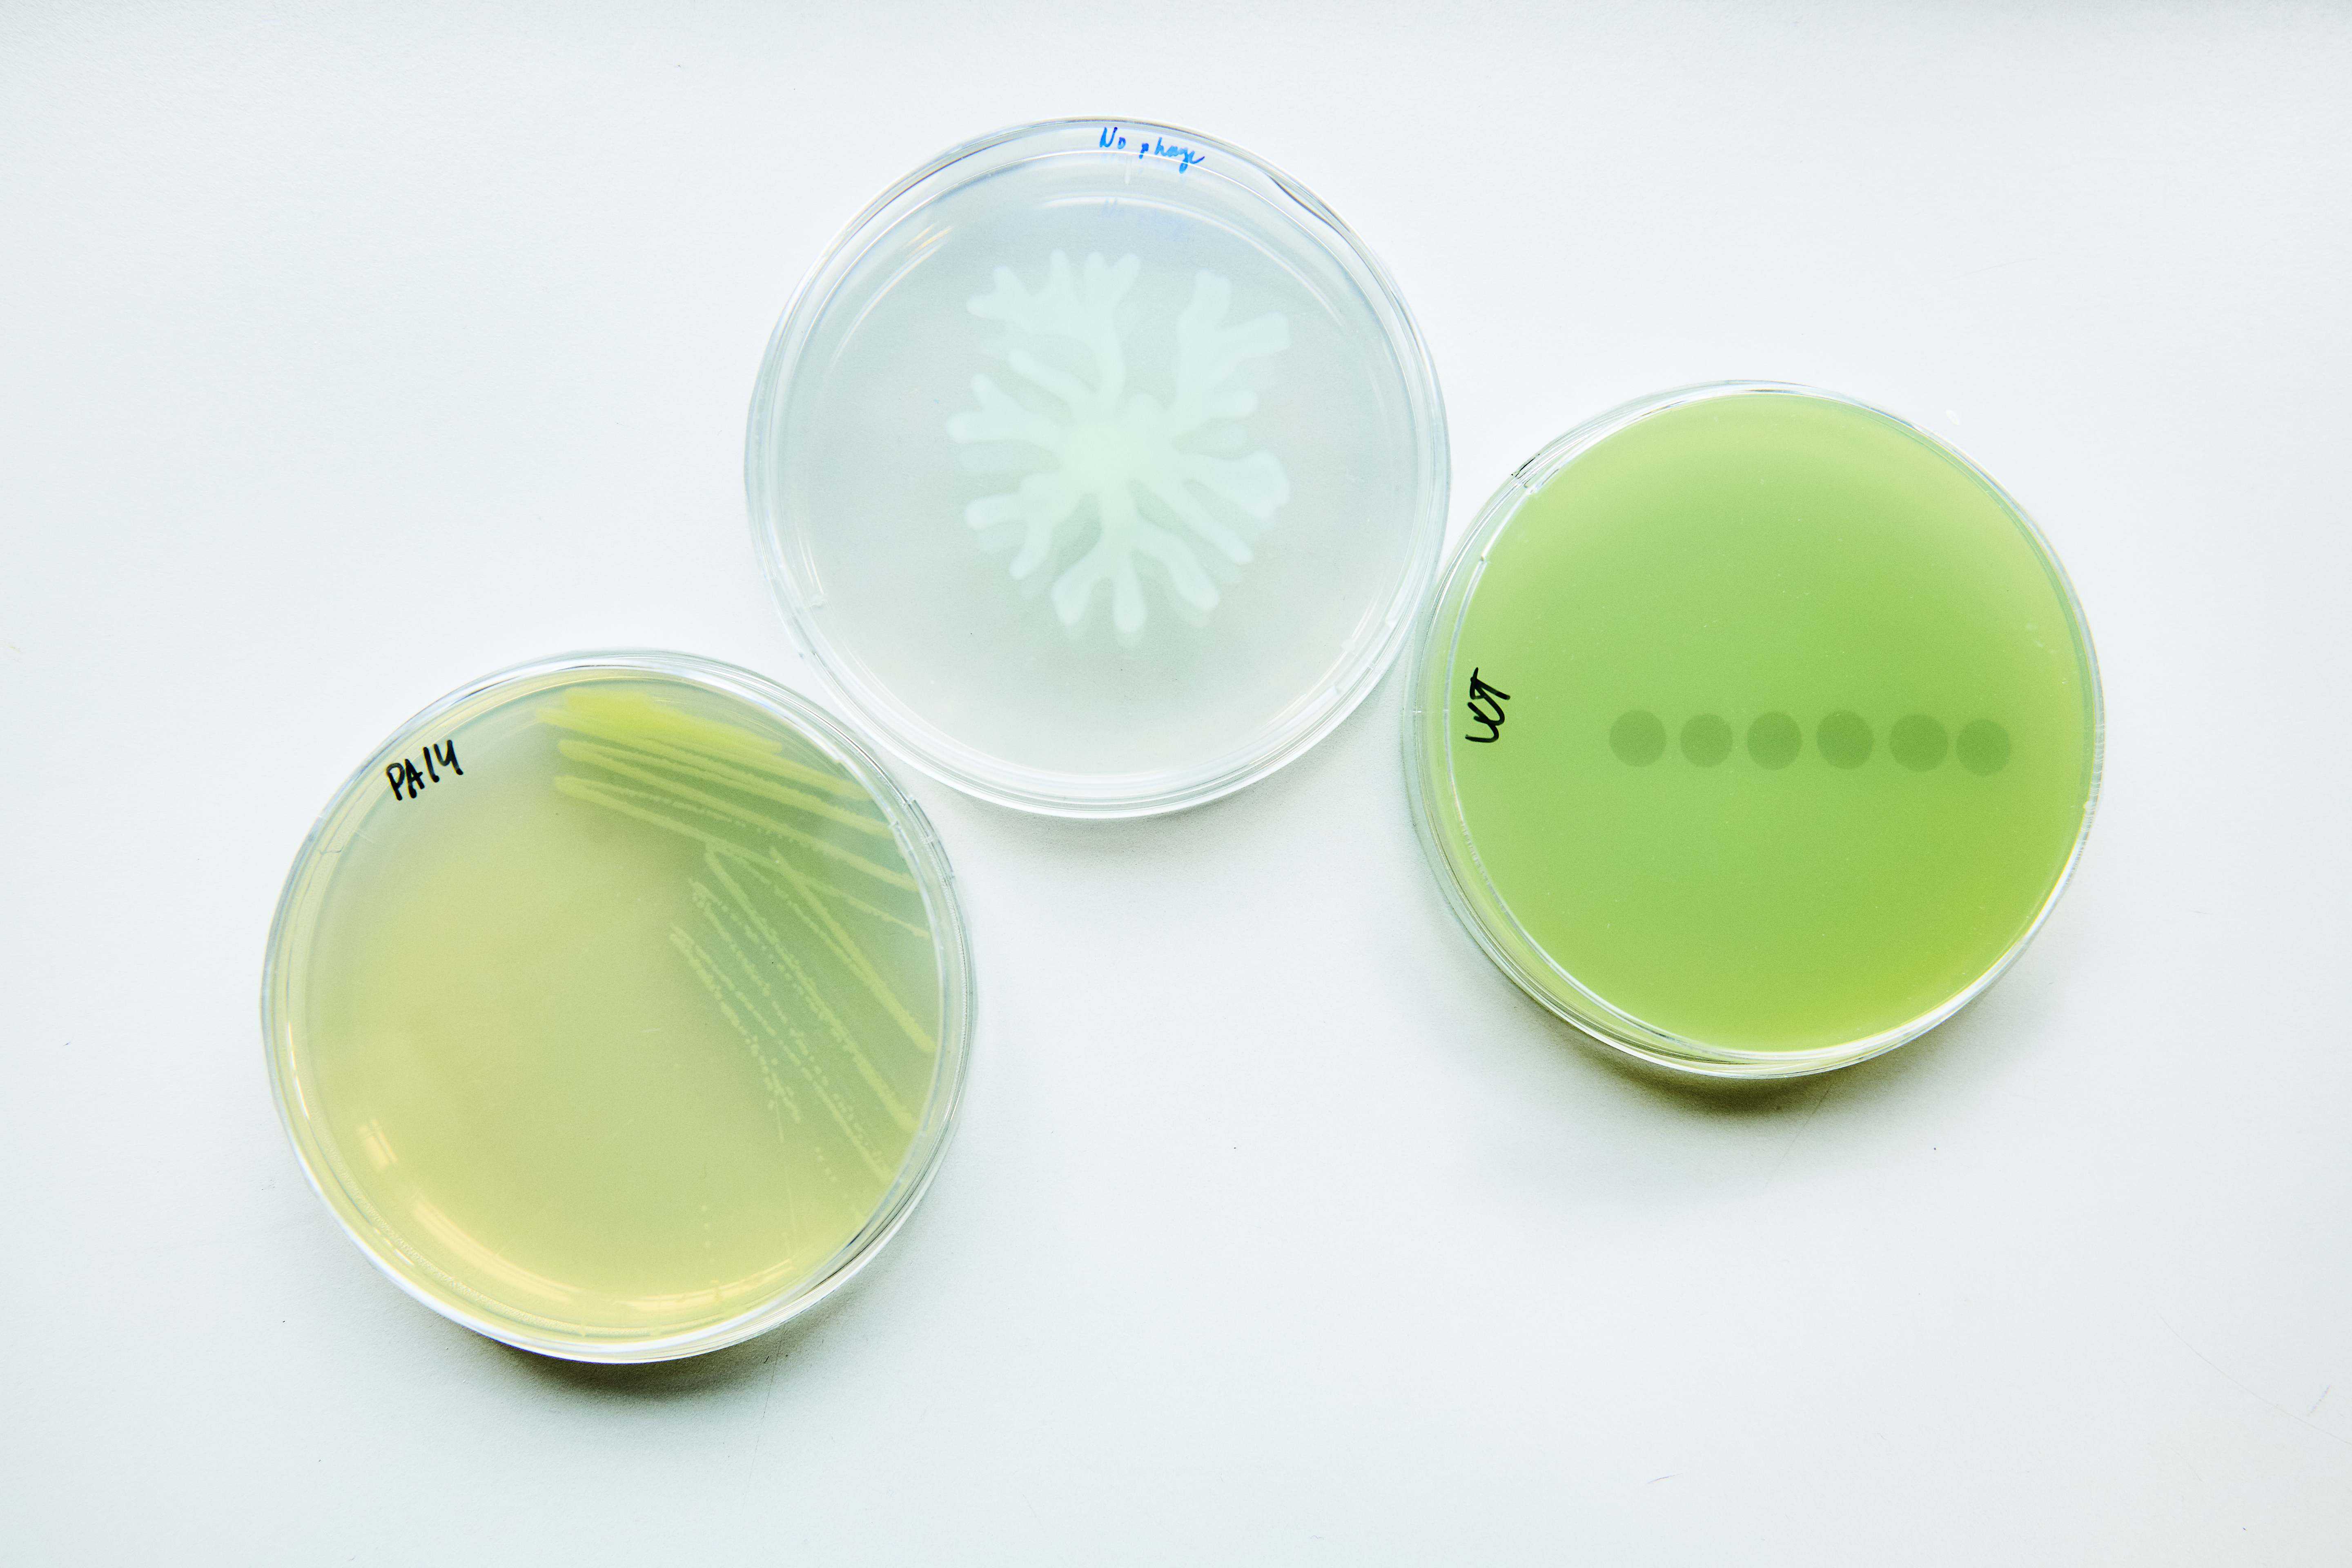

Events and networks
Do you want to strengthen your skills, expand your network and be inspired in your working life? Participate in events and networks in Pharmadanmark.

Do you need help?
Whether you're navigating your first job, looking for new opportunities, or facing challenges in your current role, our career advisors are ready to support you.
Get guidance tailored to your situation – from job applications and salary negotiations to long-term career planning.
Email: karriere@pharmadanmark.dk
Phone: +45 3946 3630
Opening hours:
Monday–Thursday: 9:30–16:00
Friday: 9:30–14:00